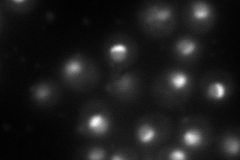
YGL120C
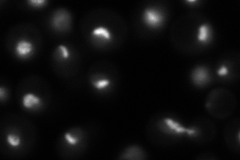
YGL120C

View description
RNA helicase in the DEAH-box family, functions in both RNA polymerase I and polymerase II transcript metabolism, involved in release of the lariat-intron from the spliceosome
Localization:
Intensity:
Fold change:
Significance:
-
C’ GFP library in SD

nucleolus104.56 -
N' NOP1pr-GFP in SD
nucleus,nucleolus171.69 -
N' TEF2pr-mCherry in SD

nucleus205.818 -
N' NATIVEpr-GFP in SD
nucleus,nucleolus100.545 -
N' TEF2pr-VC and Cyto-VN in SD

#N/A0 -
C’ GFP library in SD+DTT

nucleolus79.860.76No -
C’ GFP library in SD+H2O2

nucleolus122.61.17No -
C’ GFP library in Starvation Media

nucleolus54.560.52Yes -
C’ GFP library on the background of Pup2-DaMP

nucleolus -
C’ GFP library on the background of CCT mutant

nucleolus127.6791.22101No
